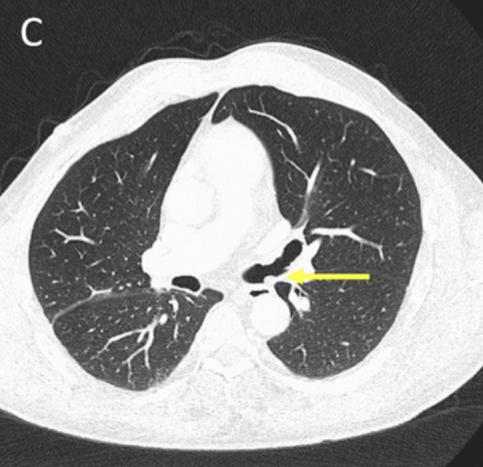

不停干咳怀疑肺癌……活检后终于松了口气
原创 玉滋 医学界风湿免疫频道 收录于合集 #风湿病例 135个
*仅供医学专业人士阅读参考
难道肿块与血管炎有关系?治疗方案怎么制定?
一名男性由于不停干咳到呼吸科就诊,检查居然发现支气管内大量肿块,快来看看是怎么一回事吧~
案例介绍
气温仍未回暖,50岁的李先生近期突然老是咳嗽,以为是春季病毒传染性感冒,自己买了点感冒药吃了,但仍然不停咳嗽。
过了好几天去社区医院看,诊断为急性支气管炎,便给开了一些抗生素,咳嗽症状完全没有缓解。直到这个咳嗽已经引起李先生生活不便,咳得胸内不适,才意识到问题不对,赶紧跑去医院呼吸科看病。
呼吸科医生询问得知李先生服用过抗生素,干咳症状依旧,导致急性咳嗽的原因太多了,感染后咳嗽、咳嗽变异性哮喘、支气管炎、肺炎、肺部肿瘤......必须得做胸部CT才能找到病因了!

图1 胸部CT
图1 胸部CT 图2. 支气管镜影像
图2. 支气管镜影像CT检查怀疑恶性肿瘤
CT检查示右后上叶实变,没有看到含气支气管影,怀疑是支气管内肿瘤导致阻塞后实变(图1 A)。支气管内膜异常也出现在中间支气管和左主支气管(图1B、1C)。支气管镜检查显示,左侧主支气管、右侧中间支气管和右上叶后段支气管有大量息肉样肿块。(图2)
多灶性支气管内肿块,呼吸科医生详细询问得知李先生长期吸烟,这下麻烦了,医生怀疑可能是肺部恶性肿瘤!
李先生也非常关心CT检查结果,看到肿块这两字就不淡定了,这可不是好兆头,表情都难显轻松。
医生连忙安抚李先生,CT检查只是一个参考,检查你哪里有问题,还是要靠组织活检来明确诊断,才能知道这肿块是个什么东西,先不用太焦虑,再去做个组织活检吧!
然而诊断过程中也需要对多灶性支气管内肿块进行鉴别诊断,包括:多灶性癌、支气管乳头状瘤病、支气管结核、多灶性类支气管癌和血管炎性假肿瘤等。
等待活检结果期间,李先生在网络上搜了大量类似结果的诊断,一会安慰自己可能只是息肉切除就好了,一会又心头一紧,恶性肿瘤的话以后该怎么办呢!
几天后,李先生的活检结果出来了,如下图所示:
 图3. 活检结果
图3. 活检结果活检检查出来了!
到底是不是癌?
据悉李医生三年前曾诊断ANCA相关性血管炎
难道肿块与血管炎有关系?
本文作者:玉滋
本文责编:卡带
版权申明
本文原创,欢迎转发朋友圈
- End -
"医学界"力求所发表内容专业、可靠,但不对内容的准确性做出承诺;请相关各方在采用或以此作为决策依据时另行核查。
原标题:《不停干咳怀疑肺癌……活检后终于松了口气》

